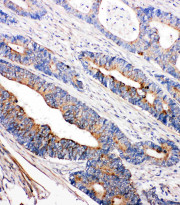

ARG58814
anti-Tec antibody
anti-Tec antibody for IHC-Formalin-fixed paraffin-embedded sections,Western blot and Human,Rat
概述
| 产品描述 | Rabbit Polyclonal antibody recognizes Tec |
|---|---|
| 反应物种 | Hu, Rat |
| 预测物种 | Ms, Hm |
| 应用 | IHC-P, WB |
| 宿主 | Rabbit |
| 克隆 | Polyclonal |
| 同位型 | IgG |
| 靶点名称 | Tec |
| 抗原物种 | Human |
| 抗原 | Synthetic peptide corresponding to aa. 612-631 of Human Tec (FEDLLRTIDELVECEETFGR). |
| 偶联标记 | Un-conjugated |
| 別名 | Tyrosine-protein kinase Tec; PSCTK4; EC 2.7.10.2 |
应用说明
| 应用建议 |
|
||||||
|---|---|---|---|---|---|---|---|
| 应用说明 | IHC-P: Antigen Retrieval: By heat mediation. * The dilutions indicate recommended starting dilutions and the optimal dilutions or concentrations should be determined by the scientist. |
属性
| 形式 | Liquid |
|---|---|
| 纯化 | Affinity purification with immunogen. |
| 缓冲液 | 0.9% NaCl, 0.2% Na2HPO4, 0.05% Thimerosal, 0.05% Sodium azide and 5% BSA. |
| 抗菌剂 | 0.05% Thimerosal and 0.05% Sodium azide |
| 稳定剂 | 5% BSA |
| 浓度 | 0.5 mg/ml |
| 存放说明 | For continuous use, store undiluted antibody at 2-8°C for up to a week. For long-term storage, aliquot and store at -20°C or below. Storage in frost free freezers is not recommended. Avoid repeated freeze/thaw cycles. Suggest spin the vial prior to opening. The antibody solution should be gently mixed before use. |
| 注意事项 | For laboratory research only, not for drug, diagnostic or other use. |
生物信息
| 数据库连接 | |
|---|---|
| 基因名称 | TEC |
| 全名 | tec protein tyrosine kinase |
| 背景介绍 | The protein encoded by this gene belongs to the Tec family of non-receptor protein-tyrosine kinases containing a pleckstrin homology domain. Tec family kinases are involved in the intracellular signaling mechanisms of cytokine receptors, lymphocyte surface antigens, heterotrimeric G-protein coupled receptors, and integrin molecules. They are also key players in the regulation of the immune functions. Tec kinase is an integral component of T cell signaling and has a distinct role in T cell activation. This gene may be associated with myelodysplastic syndrome. [provided by RefSeq, Jul 2008] |
| 生物功能 | Non-receptor tyrosine kinase that contributes to signaling from many receptors and participates as a signal transducer in multiple downstream pathways, including regulation of the actin cytoskeleton. Plays a redundant role to ITK in regulation of the adaptive immune response. Regulates the development, function and differentiation of conventional T-cells and nonconventional NKT-cells. Required for TCR-dependent IL2 gene induction. Phosphorylates DOK1, one CD28-specific substrate, and contributes to CD28-signaling. Mediates signals that negatively regulate IL2RA expression induced by TCR cross-linking. Plays a redundant role to BTK in BCR-signaling for B-cell development and activation, especially by phosphorylating STAP1, a BCR-signaling protein. Required in mast cells for efficient cytokine production. Involved in both growth and differentiation mechanisms of myeloid cells through activation by the granulocyte colony-stimulating factor CSF3, a critical cytokine to promoting the growth, differentiation, and functional activation of myeloid cells. Participates in platelet signaling downstream of integrin activation. Cooperates with JAK2 through reciprocal phosphorylation to mediate cytokine-driven activation of FOS transcription. GRB10, a negative modifier of the FOS activation pathway, is another substrate of TEC. TEC is involved in G protein-coupled receptor- and integrin-mediated signalings in blood platelets. Plays a role in hepatocyte proliferation and liver regeneration and is involved in HGF-induced ERK signaling pathway. TEC regulates also FGF2 unconventional secretion (endoplasmic reticulum (ER)/Golgi-independent mechanism) under various physiological conditions through phosphorylation of FGF2 'Tyr-215'. May also be involved in the regulation of osteoclast differentiation. [UniProt] |
| 细胞定位 | Cytoplasm. Cell membrane; Peripheral membrane protein. Cytoplasm, cytoskeleton. Following B-cell or T-cell receptors activation by antigen, translocates to the plasma membrane through its PH domain. Thrombin and integrin engagement induces translocation of TEC to the cytoskeleton during platelet activation. In cardiac myocytes, assumes a diffuse intracellular localization under basal conditions but is recruited to striated structures upon various stimuli, including ATP (By similarity). [UniProt] |
| 预测分子量 | 74 kDa |
| 翻译后修饰 | Following B-cell or T-cell receptors engagement, translocates to the plasma membrane where it gets phosphorylated at Tyr-519. Undergoes also tyrosine phosphorylation during platelet activation. [UniProt] |
检测图片 (3) Click the Picture to Zoom In
-
ARG58814 anti-Tec antibody IHC-P image
Immunohistochemistry: Paraffin-embedded Human intestinal cancer stained with ARG58814 anti-Tec antibody.
-
ARG58814 anti-Tec antibody WB image
Western blot: Rat liver, Rat spleen, Rat kidney, HeLa and Jurkat cell lysates stained with ARG58814 anti-Tec antibody.
-
ARG58814 anti-Tec antibody IHC-P image
Immunohistochemistry: Paraffin-embedded Rat liver stained with ARG58814 anti-Tec antibody.